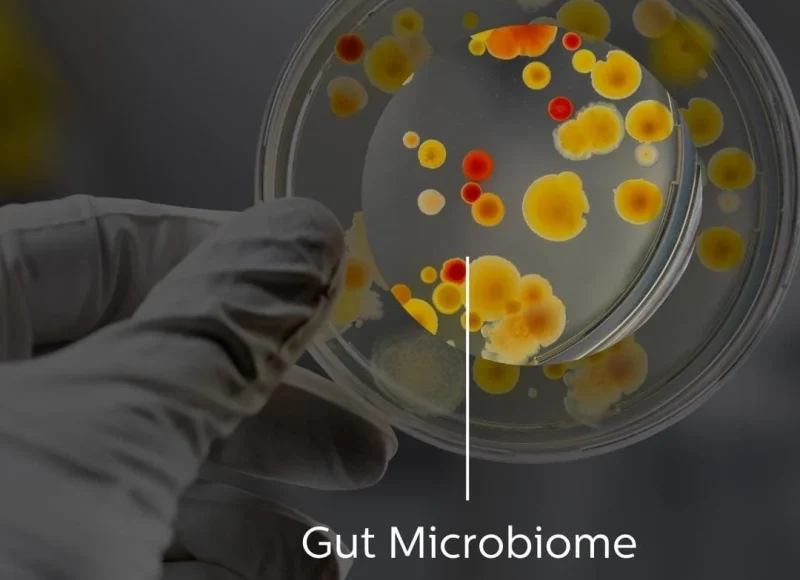
GutMicrobiomeTest

Detox backed by science


About DetoxClinic
Discover the future of wellness with science-backed detox therapies designed to cleanse your body, recharge your energy, and restore balance.
Our curated therapies from IV drips and infrared saunas to compression detox and hydrogen therapy are designed for modern professionals who want fast, effective, and lasting results.
Optimize Health Care Services
Speed Up
Returns

Why Choose Us
When it comes to your health, you deserve the highest standards of care. Here’s why thousands trust us with their detox journey:
Explore Detox Programs
At detoxclinic.co, we offer specialized programs designed to target the root cause of fatigue, poor digestion, and toxin overload. From Gut Detox and Blood Cleansing to Heavy Metal and Foot Detox, each program is doctor-supervised and science-backed. Our therapies combine modern medical innovation with natural healing to help you reset digestion, strengthen immunity, boost energy, and restore balance — so you can feel lighter, healthier, and more vibrant every day.
Renew (Signature Rejuvenation Program)
“Time to Renew, Recharge your body, refresh your mind & restore your glow with our patented Renew Program.”
Our Renew Program is a holistic rejuvenation journey that combines the best of detox, hydration, and cellular repair. With a mix of colon cleansing, IV nutrition, infrared sauna, lymphatic drainage, and relaxation therapies, Renew restores balance, vitality, and youthful energy leaving you refreshed inside out.
Explore Our Therapies
Personalized insoles designed to improve posture, balance, and overall body alignment.
Functional Diagnostic Tests
What Our Patients Say About Our Medical

Aditya
Software Developer

Meera
Working Mom

Neha
Homemaker